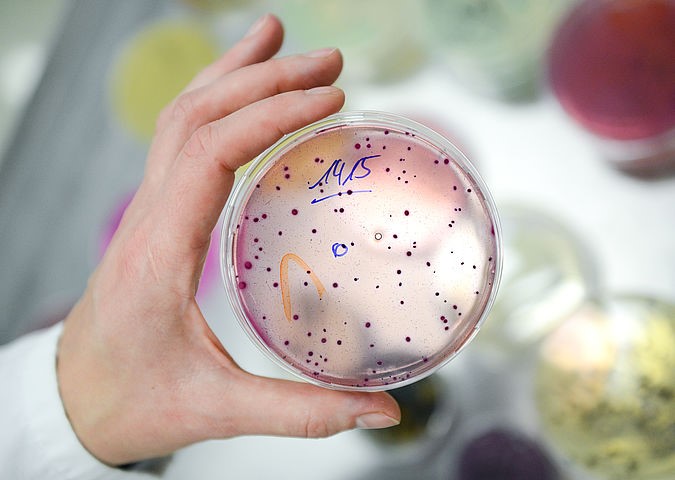

Ziua Mondială a Siguranţei Alimentelor este sărbătorită astăzi, la nivel internațional, sub egida mesajului „Hrană sigură astăzi, pentru un mâine sănătos”.
Mesajul din acest an subliniază beneficiile imediate dar și pe termen lung a producției și consumului de alimente sigure asupra oamenilor, economiei și întregii planete. El își propune să atragă atenţia asupra prosperitatii economice, dar și a unei tranziții către o dezvoltare durabilă.
Decizia privind marcarea anuală, la 7 iunie, a unei Zile Mondiale a Siguranţei Alimentare a fost luată de Adunarea Generală a Organizaţiei Naţiunilor Unite în decembrie 2018 (Rezoluţia 73/250), recunoscând astfel povara globală a bolilor provocate de alimentaţie, care afectează persoanele de toate vârstele.
Cu toții suntem consumatori de alimente și cu toții dorim ca alimentele noastre să fie sigure… De ce?
Bolile alimentare variază de la ușoare la foarte grave și pot duce chiar la deces. Din perspectivă socială, ele contribuie la absenteismul de la școală și de la muncă și reduc productivitatea . Dacă ne unim împreună pentru a încorpora bunele practici de siguranță alimentară în viața noastră de zi cu zi, putem preveni bolile de origine alimentară și putem promova productivitatea.
Fiecare persoană are un rol de jucat – indiferent dacă creșteți, procesați, transportați, depozitați, vindeți, cumpărați, pregătiți sau serviți mâncarea – siguranța alimentelor este în mâinile dumneavoastră.
„Food safety is everyone’s business”, un memento potrivit căruia cu toţii avem un rol în păstrarea siguranţei alimentelor de-a lungul întregului lanţ de aprovizionare, de la fermă până la masa.
Sloganul pentru Ziua Mondială a Siguranței Alimentare în 2022 este „Safer food, better health” („Mâncare mai sigură, sănătate mai bună”), atrăgând atenţia în privinţa nevoii de îmbunătăţire a sănătăţii umane şi în privinţa nevoii de prevenire, detectare şi gestionare a riscurilor transmise prin alimente.
Trebuie să acordăm prioritate siguranței alimentare de-a lungul întregului lanț de aprovizionare, de la fermă până la masa consumatorului. Cu toții putem lua măsuri!

Dacă nu este sigur,nu este mâncare!
Consumatorii cer mult mai mult de la mâncarea lor în ceea ce privește calitatea, prețul, valoare nutritivă și disponibilitate . Sectorul alimentar a răspuns acestor nevoi de produse și informații prin inovare, prin ingrediente noi, tehnologii, produse alimentare și conexe.
Nu există siguranță alimentară fără hrană sigura. Numai când mâncarea este sigură se vor asigura nevoile nutriționale și ajută consumatorii să trăiască o viață activă și sănătoasă și copii să crească si sa se dezvolte.
Autoritatea Națională Sanitară Veterinară și pentru Siguranța Alimentelor este instituția din țara noastră care prin rolul de reglementare în domeniul siguranței alimentelor, acțiunile de prevenire, depistare și gestionare a riscurilor alimentare contribuie la protejarea sănătății umane.

Această misiune este îndeplinită zi de zi, 24 de ore din 24, prin munca dedicată a angajaţilor săi: medici veterinari, medici umani, chimişti de industrie alimentară, biologi şi alți specialişti din diferite domenii, profesionişti care funcţionează ca o adevărată echipă, prin îmbinarea şi completarea cunoştinţelor şi experienţei lor.

Sistemul Rapid de Alertă pentru Alimenete și Furaje (SRAAF) este instrumentul specific de comunicare și acțiune rapidă utilizat în prezent de Autoritatea Naţională Sanitară Veterinară şi pentru Siguranţa Alimentelor (ANSVSA) în situația depistării unor alimente cu risc pentru sănătatea consumatorilor. Acesta permite gestionarea în mod eficient și coordonat a acestor situații, ca răspuns la o ameninţare a sănătăţii umane, cauzată de alimente.
„Direcţiile Sanitare Veterinare şi pentru Siguranţa Alimentelor au o misiune clară de monitorizare şi control, de creare a unui climat de încredere între producători şi consumatori. Acest rol este cu atât mai important cu cât România, ca stat membru al Uniunii Europene, face parte dintr-o piaţă comună care aplică unele dintre cele a exigente standarde din lume în materie de siguranţă alimentară, protecţia animalelor, protejarea mediului. Direcția Sanitară Veterinară şi pentru Siguranţa Alimentelor Vaslui transmite pe această cale că în toate acțiunile sale promovează cooperarea și colaborarea cu toate părțile implicate și interesate, pentru că doar împreună se pot asigura si promova alimente sigure pentru consum și o viață mai sănătoasă.”, a transmis dr. Mihai Ponea, directorul executiv al DSVSA Vaslui.








